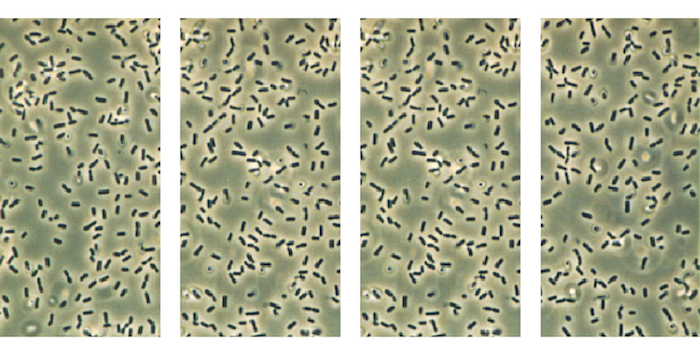

JBEI researchers are interested in understanding how lignin is degraded and mineralized in nature, so they can develop lignin deconstruction technologies that can be deployed in a lignocellulosic biorefinery. To better understand microbial lignin degradation, scientists isolated a library of microbes able to grow on lignin as a sole carbon source, then sequenced their genomes at the Joint Genome Institute (JGI).
PLEASE NOTE: To access the isolate genome information on the Integrated Microbial Genomics (IMG) website, users must create an IMG or JGI SSO account.